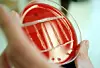
Foto: Colourbox

Afdød var smittet med listeria fra kommunekøkken
Listeriabakterier fra fire kommuners fælles køkken har formentlig smittet en mand, der nu er død.
En ny sammenkøring af registre viser, at en mand i september sidste år med høj sandsynlighed blev smittet med listeria fra Elbokøkkenet, som er et fælles køkken, der leverer mad til Kolding, Haderslev, Middelfart og Fredericia Kommuner. Det skriver jv.dk.
Manden havde listeriose, som er den sygdom, som listeriabakterier kan udløse. Han er nu død. Statens Serum Institut kan dog ikke oplyse, om listeria-infektionen var årsagen til mandens død. Instituttet kan heller ikke komme med nærmere oplysninger om manden.
Køkken har haft store problemer med listeria
Elbokøkkenet har i foråret haft store problemer med listeriabakterier. En sammenkøring af Fødevarestyrelsens og Statens Serum Instituts registre viser, at den afdøde mand i september blev smittet med en listeriabakterie, der er identisk med en listeriabakterie, der er fundet i Elbokøkkenet.
– Jeg kan bekræfte, at den afdøde havde listeriose med samme type listeria, som der har været i Elbokøkkenet, siger Eva Rosenørn, der er sektionsleder ved Fødevarestyrelsen Sydjylland til jv.dk.
Det er derfor med meget stor sandsynlighed mad fra Elbokøkkenet, der har smittet den afdøde mand.
– Enkeltstående sygdomssager er stort set umulige at efterforske, men da vi tog prøver i Elbokøkkenet i påsken, blev der lavet en test. Den viste 100 procent overensstemmelse mellem bakteriestammen fra Elbokøkkenet og det Statens Seruminstitut havde på den pågældende patient, siger Eva Rosenørn.
Elbokøkkenets bestyrelsesformand Kaj Johansen er ked af situationen og siger, at køkkenet gør præcis som Fødevarestyrelsen foreskriver.











